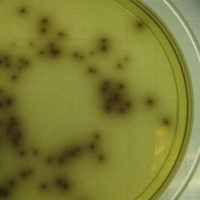

News
-
January 10, 2018Zambia’s Cholera Outbreak Spreads Fear
-
January 09, 2018South Africa: Listeriosis Death Toll 61
-
January 08, 2018Mega-Battery Activated in Australia
-
January 05, 2018Zambia: Cholera Found in Restaurants
-
January 05, 2018The World’s ‘Poorest’ President
-
January 03, 2018Crocodile Mauls Tourists in Zimbabwe
-
December 29, 2017Weah Wins Liberia Election
-
December 29, 2017Zambian Government to Pilot a CFS App
-
December 27, 2017Mnangagwa To Hunt Mugabe’s Allies
-
December 21, 2017The Most Peaceful Countries in Africa 2017